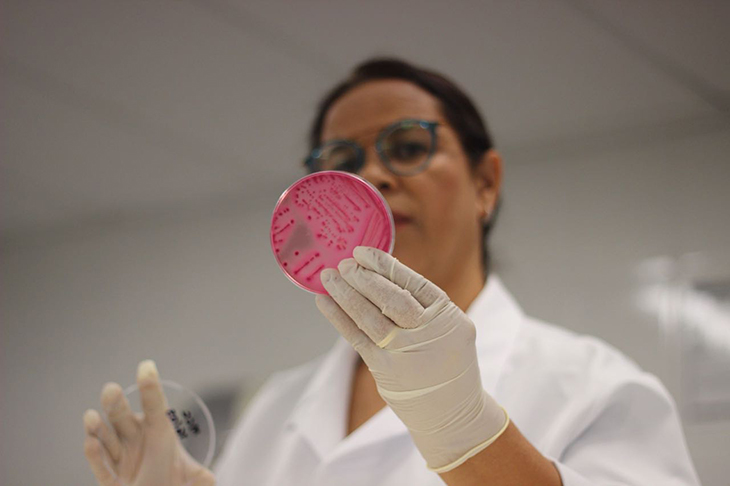
rosanasiq02

Veja o que fazer para afastar os insetos de casa e preservar a saúde
Um estudo brasileiro recente revelou que só uma barata pode conter mais de 250 milhões de fungos e bactérias, causadores de diversas doenças.
Assistir um filme sob o edredom, comendo pipoca em um dia frio... Bom demais, não é? As baratas, as moscas e as formigas também adoram (estamos falando daqueles minúsculos farelos com gordura, sal ou açúcar que você deixa na cama, no sofá ou no chão da sua casa).
São hábitos inocentes como esses que podem atrair insetos para o ambiente doméstico. E que mal eles podem nos causar, além de um pouco de nojo ou fobia?
Esses bichinhos (que nunca estão sozinhos) podem transportar milhões de fungos e bactérias que podem causar diversas doenças, como constatou um recente estudo realizado na Universidade Metrocampo/Wyden, em Campinas (SP).
A pesquisa chegou a impressionantes números: em apenas uma barata, foram encontrados cerca de 250 milhões de fungos de bactérias. Nas moscas foram detectados 72 milhões; já nas formigas, 13 milhões.
Dicas para cuidar da sua saúde e viver melhor
Como foi feito o estudo
Para realizar a pesquisa, foram coletados 40 insetos vivos – entre baratas, moscas e formigas. A equipe de pesquisa deu um “banho” nesses bichinhos com uma solução salina para esterilizá-los, das antenas às patinhas. Por fim, essa água foi colocada em meios de cultura para análises.
Foram encontradas bactérias como Salmonella e Escherichia coli, causadoras de diarreia, vômito e febre, fungos como Candida albicans, que provoca candidíase, e Rhodotorula, associado a micoses e até meningite.
As quantidades verificadas são capazes de causar doenças não só em pessoas imunodeprimidas, como idosos, doentes internados em hospitais e crianças pequenas, mas em pessoas saudáveis.
Cuidados com a limpeza são fundamentais
A PROTESTE conversou com Rosana Siqueira (foto abaixo), bióloga, Mestre e Doutora em Ciência de Alimentos pela Unicamp, que coordenou o estudo, para entender melhor como podemos afastar insetos de nossas casas e preservar nossa saúde. As fotos da Professora Rosana foram feitas por Giovanna Frederico

PROTESTE - Se uma barata tiver contato com copos, pratos e talheres, basta lavá-los com detergente?
Profª Rosana Siqueira – Uma barata andando pela cozinha ou diretamente nas louças requer atenção maior. É muito importante lavar bem os copos e os pratos usando água limpa, detergente e uma esponja de cozinha. Após a lavagem, se for possível, ferver água e jogar nesses utensílios.
A água quente reduz a contaminação que ainda possa ter ficado após a lavagem. Lembrando que a própria esponja pode estar contaminada. No final do dia, é recomendável higienizá-la com água fervente e retirando toda água dela. Guarde-a sempre em local limpo e seco. As esponjas podem abrigar restos de alimentos e umidade, tornando-se um ninho para micro-organismos.
Dicas sobre higiene na cozinha
PROTESTE - E se o consumidor encontra uma formiga em um pé de alface. Nem a lavagem com água sanitária ou soluções de higienização consegue descontaminar a alface?
Rosana – O pé de alface, assim como qualquer outra verdura, é um alimento que, durante seu plantio, pode entrar em contato com água de irrigação e com adubos que podem estar muito contaminados. Dessa forma, ela pode conter muitos micro-organismos, como bactérias, fungos, vírus e até mesmo parasitas. O contato desse alimento com formigas pode aumentar essa contaminação.

É fundamental que, antes de colocar as folhas de alface em solução de água sanitária, por exemplo, as folhas sejam bem lavadas em água corrente potável. Quando as verduras são lavadas, parte da contaminação existente nas folhas é eliminada.
Quando são imersas de 15 a 20 minutos em solução de água sanitária, a redução acaba deixando essas folhas a nível seguro para o consumidor. Por isso, a lavagem antes de colocar na solução é muito importante.
Tomates, pepinos e rabanetes, por exemplo, que são consumidos habitualmente com a casca, devem ser bem lavados, pois os micro-organismos ficam aderidos na superfície.
PROTESTE - Esses insetos podem ter contato com plantas do jardim. Eles também deixariam rastros de contaminação em plantas, como ocorre com os alimentos? Em contato com plantas, podemos nos contaminar e adoecer?
Rosana – Apenas o contato não é suficiente para deixar uma pessoa doente. Para que isso ocorra, os micro-organismos presentes nas plantas terão que invadir o corpo do indivíduo, seja por um furo da pele ocasionado por espinhos presentes nas plantas ou caso a pessoa já tenha um machucado.
Em geral, com a pele intacta, o que pode acontecer é a pessoa desenvolver um processo alérgico, pois dificilmente os micro-organismos terão portas de entrada.
No entanto, pessoas que mexem com terra durante o plantio acabam ficando mais suscetíveis à contaminação, pois estão mais em contato com o solo e as plantas e, assim, podem se ferir com os espinhos ou farpas, principalmente se não usarem luvas ou sapatos fechados, como botas.

PROTESTE - Cite outros cuidados importantes que devemos ter em nossa casa para afastar esses bichinhos?
Rosana – Tome cuidado com o lixo e a lixeira da cozinha. É fundamental retirar sempre o lixo após terminar as atividades, de manhã, à tarde e à noite, e lavar a lixeira, deixando-a sempre limpa, seca e fechada. É importante deixá-la no chão, e não sobre a pia, que também precisa estar limpa e seca.
Em casas com crianças, evite deixar cair na pia creme dental com aroma adocicado, pois isso atrai formigas e outros bichos que acabam passeando por todo o ambiente contaminando, como paredes, piso, vaso sanitário e até outros utensílios que deixamos sobre ela, como a escova dental.
Como utilizar produtos de limpeza com segurança
Durante o preparo das refeições, sempre deixe tampadas as carnes temperadas, as panelas com os alimentos prontos, verduras e legumes e jarra de suco para evitar que moscas pousem sobre esses alimentos. Guarde os alimentos com suas embalagens devidamente fechadas, principalmente açúcar, biscoitos, bolos e outros alimentos.
Limpe sempre gavetas e armários onde ficam os alimentos, assim como as gavetas onde ficam os talheres e os armários onde são guardados os copos e os pratos. As refeições devem ser feitas em ambiente apropriado e não no quarto e na sala.
Após as refeições, a mesa deve ser limpa com álcool 70% ou outro produto de limpeza, desde que não danifique o móvel. Evite borrifar no ambiente um produto com aroma adocicado, isso pode atrair insetos como formigas, baratas, moscas e até abelhas.
Gostou deste conteúdo? Cadastre-se agora e receba gratuitamente informações da PROTESTE! Se você é associado e precisa de ajuda, ligue para nosso Serviço de Defesa do Consumidor pelo 0800 282 2204 (de telefone fixo) ou (21) 4003-3907 (de celular).